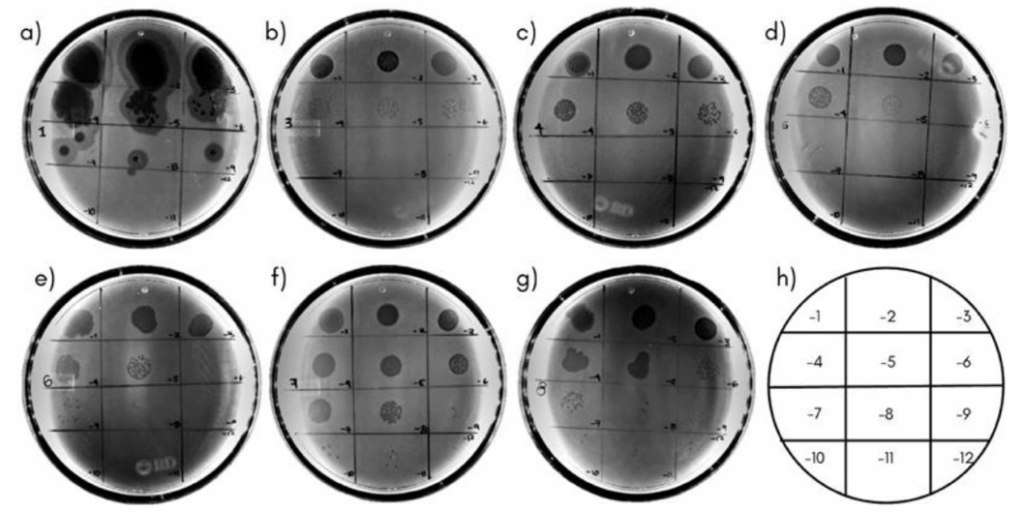

Héroes invisibles: virus que luchan contra las bacterias resistentes a los antibióticos
Actualmente el planeta se encuentra ante un desafío de salud, una amenaza invisible: bacterias dotadas de un arsenal de armamento que han generado para poder subsistir a los ataques recurrentes e indiscriminados con antibióticos y a otros agentes que ponen en juego su existencia (figura 1). Esto ha permitido que las bacterias y otros microorganismos resistan y se multipliquen en los humanos y los animales y lleguen a contaminar el ambiente, causando un desequilibrio y la pérdida de la salud en los ecosistemas. Este fenómeno es denominado resistencia antimicrobiana (RAM), la cual se define como la capacidad que tienen los microorganismos, como las bacterias, para desarrollar mecanismos que les permiten resistir a los tratamientos antimicrobianos anteriormente efectivos, por lo cual es considerada una pandemia silenciosa.

Figura 1. Bacteria resistente a los antibióticos.
En 2019 más de 1.2 millones de personas murieron por infecciones asociadas a la RAM, y la cifra sigue aumentando (Pirnay et al., 2024), lo que da como resultado infecciones persistentes y difíciles de tratar y un aumento del riesgo de propagación de estas, prolongando su duración, el tratamiento y la letalidad de las enfermedades ocasionadas, con implicaciones socioeconómicas graves en materia de salud, lo cual exige un enfoque integral para su atención.
Entre las bacterias más peligrosas destaca Pseudomonas aeruginosa, un microorganismo capaz de sobrevivir en hospitales y resistir múltiples antibióticos (WHO Bacterial Priority Pathogens List, 2024). Esta bacteria afecta especialmente a pacientes con defensas bajas o que dependen de dispositivos médicos, como catéteres o respiradores. En los hospitales se convierte en un enemigo persistente al formar biopelículas —comunidades bacterianas que se adhieren a superficies—, dificultando su eliminación. Su impacto no se limita al entorno hospitalario, ya que Pseudomonas aeruginosa es considerada uno de los seis patógenos bacterianos prioritarios a nivel mundial, junto con E. coli, S. aureus, K. pneumoniae, S. pneumoniae y A. baumannii, responsables del 18.8 % de las muertes globales asociadas a la RAM).
Comprender el alcance y la gravedad de la RAM en P. aeruginosa es crucial, dada su relevancia como bacteria oportunista y una de las principales causantes de infecciones asociadas a la atención en salud (IAAS) (Asmare et al., 2024).
La situación es tan preocupante que la Organización Mundial de la Salud (OMS) la ha catalogado como una amenaza prioritaria, llamando a desarrollar nuevas estrategias terapéuticas antes de que los antibióticos dejen de funcionar por completo (Jurado-Martín et al., 2021).
Ante la creciente ineficacia de los antibióticos, la ciencia busca nuevas formas de combatir a las bacterias resistentes. Entre las estrategias exploradas están vacunas, moléculas antimicrobianas naturales y tratamientos que bloquean la comunicación entre bacterias. Sin embargo, ninguna ha reemplazado completamente a los antibióticos en hospitales (Sathe et al., 2023).
Una opción que destaca es la fagoterapia: el uso de bacteriófagos, virus diminutos que solo infectan y destruyen bacterias (figura 2). Cuentan con una sorprendente precisión: mientras los antibióticos afectan tanto a bacterias malas como buenas, los fagos actúan como francotiradores microscópicos, atacando solo a su objetivo sin dañar nuestra microbiota y con pocos efectos secundarios (Kim et al., 2025).

Figura 2. Ilustración de los bacteriófagos; ejemplo de cómo infectan a la bacteria.
Hoy la investigación va más allá de usar combinaciones estándar de fagos. La fagoterapia personalizada selecciona virus capaces de atacar exactamente a la bacteria que causa la infección en cada paciente. Para ello se necesitan bancos de fagos bien caracterizados, con protocolos que aseguren su seguridad y eficacia (Żaczek et al., 2025).
Este enfoque promete aumentar las tasas de éxito clínico, especialmente en escenarios donde los antibióticos han perdido eficacia. No obstante, enfrenta varios desafíos importantes, entre ellos la ausencia de normas internacionales unificadas, la producción compleja y costosa a pequeña escala y el acceso limitado a bancos de fagos validados.
Por eso, generar colecciones locales de fagos específicos es clave para desarrollar tratamientos rápidos y efectivos adaptados a los patógenos de cada hospital (figura 3).

Figura 3. Imagen representativa un banco de fagos caracterizados.
En ese contexto, en un estudio realizado en el Centro de Investigación en Alimentación y Desarrollo (CIAD) se aislaron siete bacteriófagos de aguas residuales hospitalarias, todos capaces de atacar cepas multirresistentes de Pseudomonas aeruginosa. Los resultados mostraron que estos virus pueden ser herramientas precisas y eficaces para diseñar tratamientos personalizados.
Cada fago cuenta con cualidades diferentes: algunos actúan muy rápido y otros poseen mayor potencia para destruir biopelículas (figura 4). Esto permitirá desarrollar cocteles fágicos adaptados a las necesidades de cada paciente o entorno hospitalario.

Figura 4. Los fagos se muestran con placas circulares en un abundante césped bacteriano; denotan ser un mismo fago por la homogeneidad de las placas observadas.
Entre los siete virus estudiados, el fago 1 se destacó por su notable velocidad de acción, ya que logra adherirse a la bacteria en cuestión de minutos. Además, mostró una alta eficacia, siendo capaz de destruir la bacteria, incluso en bajas cantidades. Asimismo, presentó indicios de actividad contra biopelículas, posiblemente mediante la acción de enzimas depolimerasas, lo que sugiere que podría ser especialmente útil en la terapia personalizada contra bacterias resistentes. Estos atributos lo convierten en un candidato ideal para tratar infecciones persistentes y para combinarlo con antibióticos tradicionales.
Un hallazgo importante es que los fagos se aislaron del mismo entorno hospitalario donde se originaron las bacterias resistentes. Esto sugiere una coevolución natural, donde estos virus seleccionados muestran adaptación para combatir a las bacterias que componen la microbiota propia de ese ambiente hospitalario (figura 5).
Aprovechar esta relación permite diseñar terapias más efectivas y sostenibles, adaptadas a la realidad de cada institución médica.
Figura 5. Diferencias significativas de cómo el fago 1 tiene una capacidad mucho mayor de infectar, además de que su morfología indica efectividad para eliminar las biopelículas.
Los resultados demuestran que incluso donde surgen las infecciones más peligrosas también pueden encontrarse soluciones. Los bacteriófagos, lejos de ser enemigos, son aliados invisibles capaces de restaurar el equilibrio frente a la resistencia a los antibióticos.
Apostar por la fagoterapia personalizada significa apostar por una medicina más inteligente, natural y adaptada a cada paciente. Aunque la implementación clínica aún tiene retos, investigaciones como esta muestran que la respuesta podría estar justo donde empezó todo: en la relación invisible entre bacterias y los virus que las combaten.

Figura 6. Representación gráfica de la actividad del fago 1, demostrada muy por encima de los demás.
Referencias
Pirnay, J.-P., Djebara, S., Steurs, G., Griselain, J., Cochez, C., De Soir, S., Glonti, T., Spiessens, A., Vanden Berghe, E., Green, S., Wagemans, J., Lood, C., Schrevens, E., Chanishvili, N., Kutateladze, M., De Jode, M., Ceyssens, P.-J., Draye, J.-P., Verbeken, G., ... Merabishvili, M. (2024). Personalized bacteriophage therapy outcomes for 100 consecutive cases: a multicentre, multinational, retrospective observational study. Nature Microbiology, 9(6): 1434-1453.
OMS (2024). WHO Bacterial Priority Pathogens List 2024: bacterial pathogens of public health importance, to guide research, development, and strategies to prevent and control antimicrobial resistance. World Health Organization.
Jurado-Martín, I., Sainz-Mejías, M. y McClean, S. (2021). Pseudomonas aeruginosa: an Audacious pathogen with an adaptable arsenal of virulence factors. International Journal of Molecular Sciences, 22(6): 3128. https://doi.org/10.3390/ijms22063128.
Sathe, N., Beech, P., Croft, L., Suphioglu, C., Kapat, A. y Athan, E. (2023). Pseudomonas aeruginosa: infections and novel approaches to treatment “Knowing the enemy” the threat of Pseudomonas aeruginosa and exploring novel approaches to treatment. Infectious Medicine, 2(3): 178-194. https://doi.org/10.1016/j.imj.2023.05.003.
Kim, M. K., Suh, G. A., Cullen, G. D., Pérez Rodríguez, S., Dharmaraj, T., Chang, T. H. W., Li, Z., Chen, Q., Green, S. I., Lavigne, R., Pirnay, J.-P., Bollyky, P. L. y Sacher, J. C. (2025). Bacteriophage therapy for multidrug-resistant infections: Current technologies and therapeutic approaches. The Journal of Clinical Investigation, 135(5): e187996. https://doi.org/10.1172/JCI187996.
Żaczek, M., Zieliński, M. W., Górski, A., Weber-Dąbrowska, B. y Międzybrodzki, R. (2025). Perception of phage therapy and research across selected professional and social groups in Poland. Frontiers in Public Health, 13: 1490737. https://doi.org/10.3389/fpubh.2025.1490737.
Asmare Z., Reta, M.A., Gashaw, Y., Getachew, E., Sisay. A., Gashaw, M. et al. (2024) Antimicrobial resistance profile of Pseudomonas aeruginosa clinical isolates from healthcare-associated infections in Ethiopia: A systematic review and meta-analysis. PLoS ONE 19(8): e0308946. https://doi.org/10.1371/journal.pone.0308946.
Autoras: Melissa Itzel González Cázarez, egresada de la Maestría en Ciencias del CIAD, y Josefina León Félix, profesora investigadora del CIAD.
CITACIÓN SUGERIDA
González Cázarez M.I. et al (2025, 29 octubre). Héroes invisibles: virus que luchan contra las bacterias resistentes a los antibióticos. Oficina de Prensa. Centro de Investigación en Alimentación y Desarrollo (CIAD). https://www.ciad.mx/heroes-invisibles-virus-que-luchan-contra-las-bacterias-resistentes-a-los-antibioticos/↗







